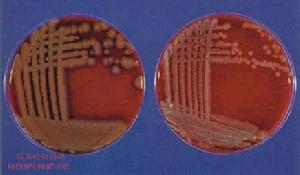
梭狀芽胞桿菌性肌壞死

疾病名稱
 梭狀芽胞桿菌性肌壞死
梭狀芽胞桿菌性肌壞死梭狀芽胞桿菌性肌壞死
疾病分類
普通外科
疾病病因
對有大血管損傷、大塊肌肉壞死、開放性骨折、深部穿入傷及有異物存留的盲管傷,應高度警惕發生氣性壞疽的可能。
疾病概述
氣性壞疽的病變是由於各種氣性壞疽桿菌侵入傷口後引起的廣泛性的肌肉壞死的一種迅速發展的嚴重性感染。各種氣性壞疽桿菌侵入傷口後引起的廣泛性的肌肉壞死的一種迅速發展的嚴重性感染。伴隨著肌肉廣泛性壞死,可有氣體或無氣體產生,伴隨著嚴重的毒血症,通常發生於開放性骨折、深層肌肉廣泛性挫傷,傷口內有死腔和異物存在或伴有血管損傷以至局部組織血供不良的傷病員,偶也可發生於擇期手術,尤其是下肢、結腸和膽囊手術後。 主要致病菌是梭狀芽胞桿菌為革蘭氏染色陽性厭氧桿菌,有許多種,但往往以產氣莢膜菌、惡性水腫桿菌和腐敗菌為主要,其次為產芽胞桿菌和溶組織桿菌等,通常是兩種以上致病菌的混合感染。故以前稱為氣性壞疽,目前稱為梭狀芽胞桿菌性肌壞死較為適當。
症狀體徵
創口突然發生劇烈脹痛,創口周圍突然腫脹或傷後早期出現毒血症症狀,如高熱、神志不清、煩躁、水腫、水皰、組織間氣腫、皮膚變色(呈蒼白、暗紅或紫黑色)、組織壞死及創口內大量屍臭味的漿液樣血性分泌物、高熱、神志不清、衰竭、黃疸等嚴重毒血症表現。
診斷檢查
1.對有大血管損傷、大塊肌肉壞死、開放性骨折、深部穿入傷及有異物存留的盲管傷,應高度警惕發生氣性壞疽的可能。
2.注意創口突然發生劇烈脹痛,創口周圍突然腫脹或傷後早期出現毒血症症狀,如高熱、神志不清、煩躁等。特別對上石膏繃帶的患者,更應密切觀察,必要時拆除石膏,檢查創口。
3.局部檢查要注意:①有無水腫、水皰、組織間氣腫(觸診有捻發音)、皮膚變色(呈蒼白、暗紅或紫黑色)、組織壞死及創口內大量屍臭味的漿液樣血性分泌物。②創口分泌物塗片,檢查有無革蘭陽性梭形芽胞桿菌,同時作細菌培養(包括厭氧菌培養),亦可行間接免疫螢光染色法和免疫酶標組化法快速測定。③早期疑有氣性壞疽時,可作X線攝片,觀察組織間有無氣體,必要時2~5h檢查1次,觀察氣體及其分布變化。
4.全身檢查應注意,①有無高熱、神志不清、衰竭、黃疸等嚴重毒血症表現。②作血培養,測血尿素氮、肌酐,必要時作總膽紅素、游離膽紅素及肝臟酶譜檢查。③測定血紅蛋白量,以確定有無進行性貧血。查尿液,注意尿膽素原、尿膽素是否增加,有無蛋白尿。
治療方案
1.立即給予抗生素,如
梭狀芽胞桿菌性肌壞死
梭狀芽胞桿菌性肌壞死2.給予高蛋白、高熱量飲食,必要時多次少量輸新鮮血,糾正水與電解質紊亂。
3.手術治療
(1)診斷確定後,應立即進行急診手術治療,手術過程中,不可用止血帶。
(2)擴大創口,進行廣泛、多處的縱行切開,切除壞死組織及受累的肌肉,切口應敞開,不應縫合,以達到通暢引流目的。用大量氧化劑(如過氧化氫、高錳酸鉀溶液)沖洗創口後,以浸透氧化劑溶液的紗布疏鬆填塞創口,並經常滴入氧化劑。
(3)固定和抬高患肢。
(4)只在肌肉廣泛壞死伴有嚴重毒血症威脅生命時,始考慮早期截肢術,截肢後,為防止創口周圍皮膚收縮,應行皮膚牽引術,截肢平面較高,殘端全層敞開,不縫合,創口處理同上,待肉芽組織長好後,再行殘端修整縫合。
4.高壓氧治療。一般採用303kPa(3atm)高壓氧,清創前進行二次高壓氧治療,可改善症狀,降低手術危險性,清創術後繼續採用高壓氧療法,如此反覆治療,同時套用大量有效抗生素直至無壞死組織和中毒症狀消失。
護理:
1.按接觸隔離常規護理,用過的敷料應予焚毀,用過的衣服、被褥均須高壓蒸氣滅菌,方可再用,傷口癒合後或創面清潔、無壞死組織、分泌物厭氧菌培養3次陰性,且全身症狀消失時,即可解除隔離。
2.對截肢患者,應作好解釋安慰工作,及時將氧化劑滴入創口內,注意皮膚牽引的效果。
3.如有高熱,則按高熱常規護理。
出院標準:
體溫與血白細胞計數下降至正常,一般情況好轉,創口癒合,即可出院。

